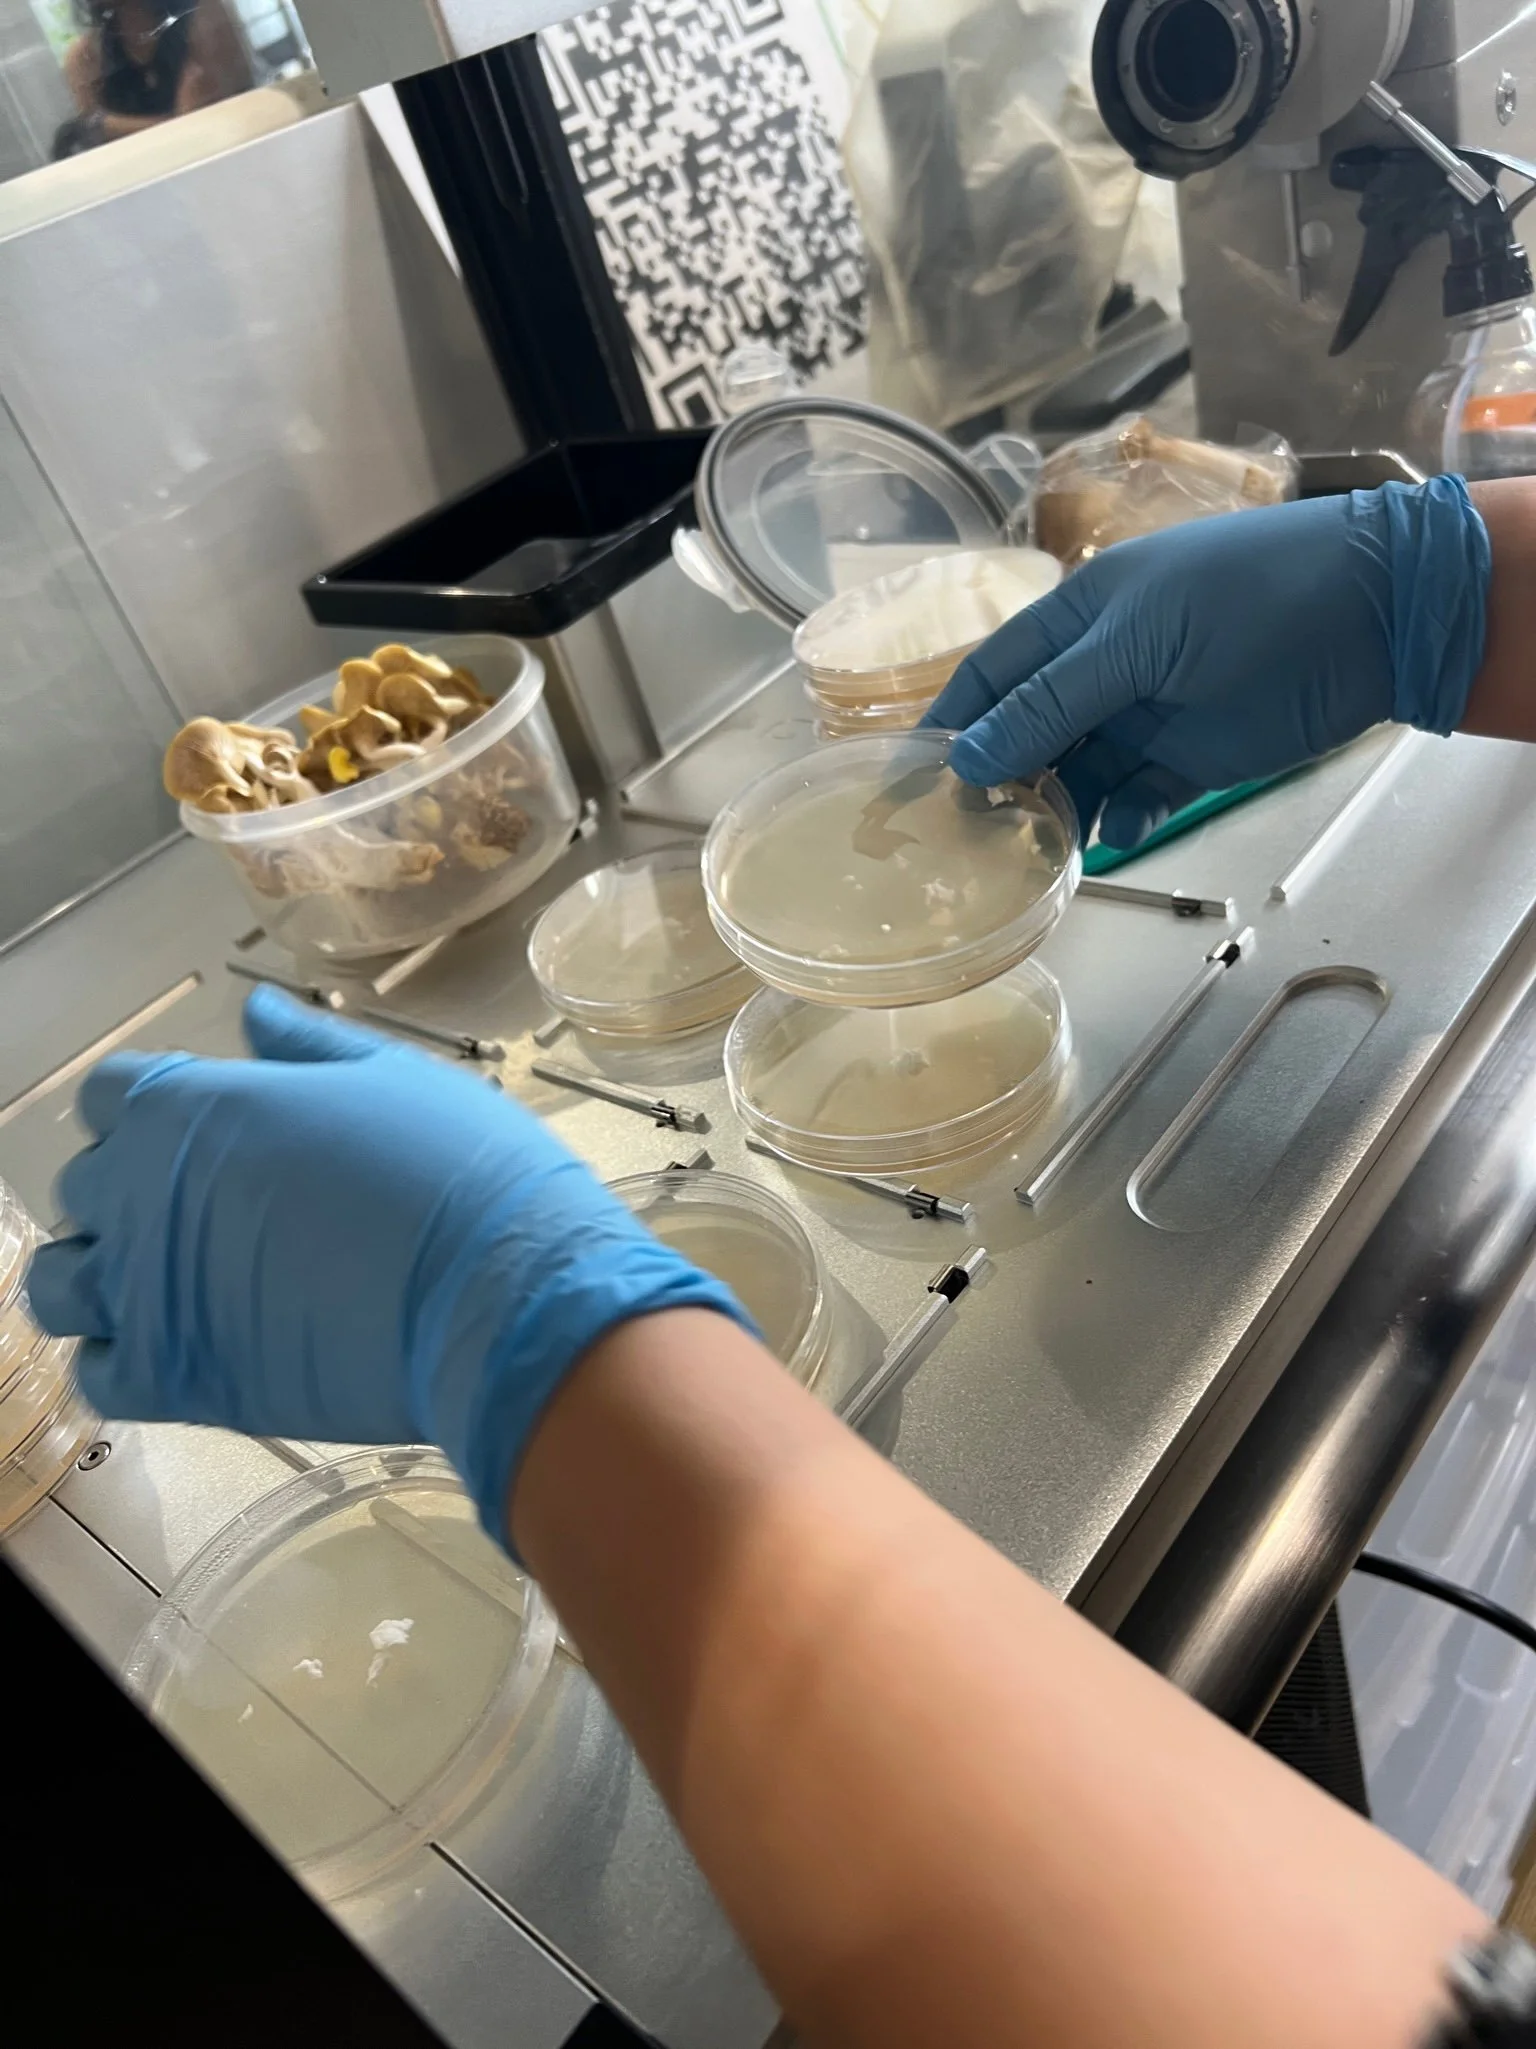
IMG_6950.JPG

Roots of Renewal
Sunset Park, Brooklyn, New York City
2024
“Roots of Renewal" was a five-week biodesign internship empowering Asian-American high school students by bringing together art, science, sustainability, and community care through the practice of building mycelium sculptures. This program connected youth to local communities, cultivated a curiosity for biodesign, and encouraged experimentation with science through creative expression.
This program was made possible through collaborations with Chinese-American Planning Council, Genspace, New York Mycological Society, and funding from Asian American Art Alliance (A4)’s What Can We Do? grant.

Week 1 - Orientation
The first week was held at Genspace, a community biology lab in Sunset Park. During the orientation, students learned about fungi, aseptic lab techniques, mushroom cloning, and activated their own mycelium using a Grow.bio Grow it Yourself kit. We then celebrated the start of the internship with a pizza party.
“Starting off the week with being at Genspace blew my mind away…The available resources were the best part of the internship as I learned about so many different opportunities in the community. I felt that I was able to continue my journey in learning about biology/design with all the resources provided. Perhaps, I’ll be able to create something that’ll provide the world with a substantial future.”
Week 2 - Sustainability and Biomaterials
During week 2, we focused on sustainability and biomaterials, which was held at ArtBuilt Studio. We started with a lecture on mycelium followed by a speaker panel of biodesigners. Then the students brainstormed and prototyped their own mycelium sculptures. The day ended with them packing their mycelium.
“My perception on science, art, and design has changed because it has made me think of other things that can replace or be made into other objects that we use daily.”
Week 3 - Mushroom Walk
The interns participated in a mushroom walk at Prospect Park with the New York Mycological Society. Students learned to observe and identify mushrooms from the park grounds. At the end of the walk, we gathered to reflect and draw in our field journals.
“After the internship, I gained a new pair of lenses for my perception of the world. A week later, I found myself going back to Prospect Park with my mother to telling her how much I have learned and the types of fungi there are under the dead logs. Types of lenses like these has helped to lift the gloom and doom on the surface.”
Week 4 - Mycelium Sculptures
We started with a recap of the mushroom walk and a lecture on fungal DNA barcoding. The students worked in groups to assemble their sculptures made from the mycelium. Every intern came up with an individual piece, which they constructed a narrative that tied together their group sculpture. They worked with various art materials to assemble together their vision.
“I can possibly start a company that uses more mycelium and makes it more well known and affordable for people ”
Week 5 - Community Showcase
We celebrated with presentations from the students of their learnings and their mycelium sculptures, a distribution of the zine that was an archive of the students’ field journals and photos from the workshops, and an awarding of certificates.
“I now understand more about mycelium and the environmental impact it has on our everyday lives.”